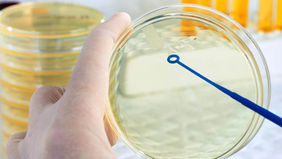

top of page

Microbiología
Nuestro servicio de microbiología identifica, mediante diversos procedimientos de laboratorio, la posible causa de las enfermedades infecciosas y los agentes antimicrobianos potencialmente efectivos; para identificar estas causas y elaborar una terapia eficaz, es imprescindible, en primer lugar, aislar e identificar los microorganismos responsables.
pruebas microbiológicas
bottom of page